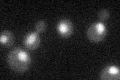
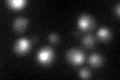

View description
Unique component of the U4/U6.U5 tri-snRNP particle, required for conformational changes which result in the catalytic activation of the spliceosome; dispensible for spliceosome assembly
Localization:
Intensity:
Fold change:
Significance:
-
C’ GFP library in SD
nucleus32.31 -
N' NOP1pr-GFP in SD

N/A0 -
N' TEF2pr-mCherry in SD

N/A0 -
N' NATIVEpr-GFP in SD

N/A0 -
N' TEF2pr-VC and Cyto-VN in SD

N/A0 -
C’ GFP library in SD+DTT
nucleus35.91.11No -
C’ GFP library in SD+H2O2

nucleus27.560.85No -
C’ GFP library in Starvation Media

nucleus33.241.02No -
C’ GFP library on the background of Pup2-DaMP

nucleus -
C’ GFP library on the background of CCT mutant

nucleus38.35381.18669No
